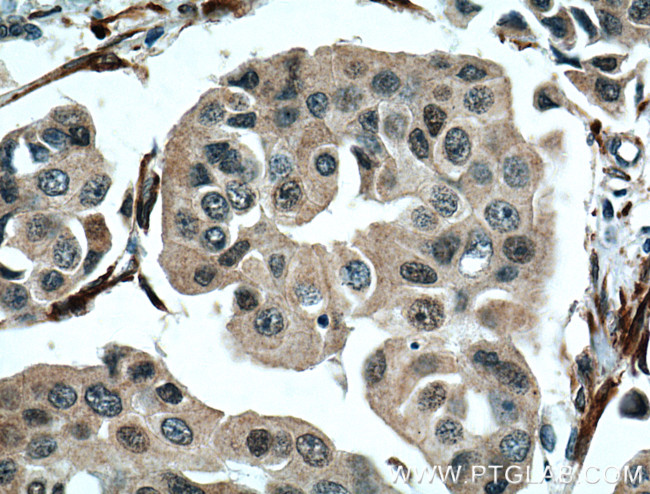
NUP155 Antibody in Immunohistochemistry (Paraffin) (IHC (P))

Search
Proteintech
NUP155 Monoclonal Antibody (1A7F2)
{{$productOrderCtrl.translations['antibody.pdp.commerceCard.promotion.promotions']}}
{{$productOrderCtrl.translations['antibody.pdp.commerceCard.promotion.viewpromo']}}
{{$productOrderCtrl.translations['antibody.pdp.commerceCard.promotion.promocode']}}: {{promo.promoCode}} {{promo.promoTitle}} {{promo.promoDescription}}. {{$productOrderCtrl.translations['antibody.pdp.commerceCard.promotion.learnmore']}}
产品信息
66359-1-IG
种属反应
宿主/亚型
分类
类型
克隆号
抗原
偶联物
形式
浓度
规格
纯化类型
保存液
内含物
保存条件
运输条件
产品详细信息
Immunogen sequence: LIQVDLADK LLQVASPFLE PHLVRMAKVD QNRVRYMDLL WRYYEKNRSF SNAARVLSRL ADMHSTEISL QQRLEYIARA ILSAKSSTAI SSIAADGEFL HELEEKMEVA RIQLQIQETL QRQYSHHSSV QDAVSQLDSE LMDITKLYGE FADPFKLAEC KLAIIHCAGY SDPILVQTLW QDIIEKELSD SVTLSSSDRM HALSLKIVLL GKIYAGTPRF FPLDFIVQFL EQQVCTLNWD VGFVIQTMNE IGVPLPRLLE VYDQLFKSRD PFWNRMKKPL HLLDCIHVLL IRYVENPSQV LNCERRRFTN LCLDAVCGYL VELQSMSSSV AVQAITGNFK SLQAKLERLH (1043-1391 aa encoded by BC039257)
靶标信息
Nucleoporins are the main components of the nuclear pore complex (NPC) of eukaryotic cells. They are involved in the bidirectional trafficking of molecules, especially mRNAs and proteins, between the nucleus and the cytoplasm. The protein does not contain the typical FG repeat sequences found in most vertebrate nucleoporins.
仅用于科研。不用于诊断过程。未经明确授权不得转售。
生物信息学
蛋白别名: 155 kDa nucleoporin; Nuclear pore complex protein Nup155; nucleoporin 155kD; nucleoporin 155kDa; Nucleoporin Nup155; P140; unnamed protein product
基因别名: ATFB15; KIAA0791; N155; NUP155
UniProt ID: (Human) O75694, (Rat) P37199
Entrez Gene ID: (Human) 9631, (Rat) 117021